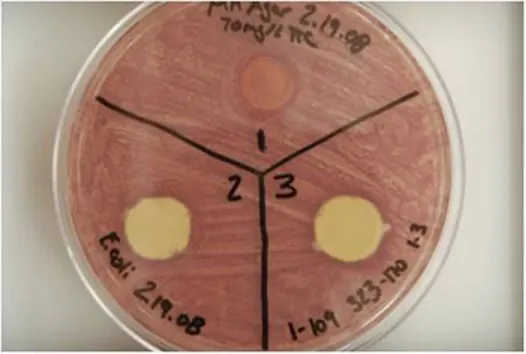

Agar Contact/Diffusion Assay
Agar Contact/Diffusion Assay

Antimicrobial coatings are prepared on glass or metal discs and placed in contact with nutrient agar plates seeded with a lawn of the appropriate microorganism. The nutrient agar contains a respiratory indicator dye (TTC), which is converted from a colorless to red compound by viable microbial cells, to visualize microbial growth on the coating surfaces. Coatings that exhibit no growth on the coating surfaces (i.e., absence of red color) and lack a zone of inhibition are determined to be contact active (samples 2 and 3 in image above).